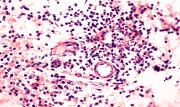

| Current Section |
IUSOM Faculty Opening in General Pathology
International University School of Medicine (IUSOM) from its all Worldwide Campuses
is Providing Medical Education and Training to All without International Borders
regardless of race, national origin, religion, sex, or age, whoever desires to devote
the extensive time and effort necessary to practice medicine. IUSOM provides a
comprehensive Basic Science and Clinical Medicine Education enabling students to
complete a Doctor of Medicine (M.D.) degree. IUSOM Main Campus and all its
Branch Campuses situated in the different parts of the world also offer Pre-Medical
(PreMed) program.
The Main Campus of International University School of Medicine (IUSOM) located in
Scenic Bonaire, Caribbean Netherlands (Dutch Caribbean), The Netherlands,
European Union (EU) has a faculty position open for teaching General Pathology for
the Basic Sciences of Doctor of Medicine (M.D.) Degree Program. IUSOM is also
accepting applications to fill-in similar faculty positions vacant at its Worldwide
Branch Campuses situated in Barranquilla (Colombia), México City (México), and
Sialkot (Pakistan).
Applicants should have an M.D. and/or a Ph.D. Degree, demonstrable teaching and
clinical experience, and good oral and written English language skills. Applicants
having lower than Ph.D. The position shall be filled at the Assistant, Associate or Full
Professor level depending upon qualifications and experience.
At IUSOM, positions are offered on a one to three year contract basis, renewable.
Faculty is responsible for course and curriculum development and members are
placed on student admission committees, promotions committees and other faculty
and administrative committees.
Applicants from U.S.A, Canada, México, South America, EU, and Asia are welcome
to apply.
Position requirements
Compensation
Applying
Interested candidates can send an application letter and a complete C.V. together
with name, mailing address, telephone number, fax number, and E.-Maill address of
at least 3 professional references, to IUSOM Headquarters and Main Campus, at
the following address:
IUSOM Headquarters and Main Campus
International University School of Medicine
Attention: Vice-President Academic
Kaya Mòfi 1
P.O. Box 59
Kralendijk
Bonaire
Caribbean Netherlands (Dutch Caribbean) 0000BQ
The Netherlands, European Union (EU)
Tel.: + 599-717-6792
Fax: + 599-717-8385
E.-Mail: admin@InternationalUniversity-SchoolOfMedicine.org
All applications will be treated with strictest confidentiality.
________________________________________________
IUSOM Main Campus and Headquarters
International University School of Medicine
Kaya Mòfi 1
P. O. Box # 59
Kralendijk, Bonaire, Caribbean Netherlands (Dutch Caribbean) 0000BQ
The Netherlands, European Union (EU)
Telephone: + 599 - 717 - 6792
Fax: + 599 - 717- 8385
CRIB (Tax) Number at Caribisch Nederland Belastingdienst: 303056514
info@InternationalUniversity-SchoolOfMedicine.org
All information is deemed reliable but is not guaranteed and should be verified
by the viewer.
Copyright © 2005 - 2505 The Trustees of International University School of
Medicine
International University School of Medicine (IUSOM) from its all Worldwide Campuses
is Providing Medical Education and Training to All without International Borders
regardless of race, national origin, religion, sex, or age, whoever desires to devote
the extensive time and effort necessary to practice medicine. IUSOM provides a
comprehensive Basic Science and Clinical Medicine Education enabling students to
complete a Doctor of Medicine (M.D.) degree. IUSOM Main Campus and all its
Branch Campuses situated in the different parts of the world also offer Pre-Medical
(PreMed) program.
The Main Campus of International University School of Medicine (IUSOM) located in
Scenic Bonaire, Caribbean Netherlands (Dutch Caribbean), The Netherlands,
European Union (EU) has a faculty position open for teaching General Pathology for
the Basic Sciences of Doctor of Medicine (M.D.) Degree Program. IUSOM is also
accepting applications to fill-in similar faculty positions vacant at its Worldwide
Branch Campuses situated in Barranquilla (Colombia), México City (México), and
Sialkot (Pakistan).
Applicants should have an M.D. and/or a Ph.D. Degree, demonstrable teaching and
clinical experience, and good oral and written English language skills. Applicants
having lower than Ph.D. The position shall be filled at the Assistant, Associate or Full
Professor level depending upon qualifications and experience.
At IUSOM, positions are offered on a one to three year contract basis, renewable.
Faculty is responsible for course and curriculum development and members are
placed on student admission committees, promotions committees and other faculty
and administrative committees.
Applicants from U.S.A, Canada, México, South America, EU, and Asia are welcome
to apply.
Position requirements
- Doctoral degree in General Pathology (e.g., M.D., Ph.D., or equivalent)
- Substantial teaching experience at a U.S., Canadian, European, Asian or
Caribbean Medical School - Strong record of excellence and commitment to teaching
- Evident interest in innovative approaches to teaching
- Candidates must be willing to relocate to the locality of IUSOM Campus
Compensation
- Position and salary will be related to the teaching experience
- Salaries comparable to International prevailing rates
- Payable direct in US dollars (US $)
- Up to 90% discount for basic tuition fee at IUSOM, to the Children (Maximum
2) of Faculty staff, who are admitted for pursuing a PreMed and/or M.D.
degree program at IUSOM
Applying
Interested candidates can send an application letter and a complete C.V. together
with name, mailing address, telephone number, fax number, and E.-Maill address of
at least 3 professional references, to IUSOM Headquarters and Main Campus, at
the following address:
IUSOM Headquarters and Main Campus
International University School of Medicine
Attention: Vice-President Academic
Kaya Mòfi 1
P.O. Box 59
Kralendijk
Bonaire
Caribbean Netherlands (Dutch Caribbean) 0000BQ
The Netherlands, European Union (EU)
Tel.: + 599-717-6792
Fax: + 599-717-8385
E.-Mail: admin@InternationalUniversity-SchoolOfMedicine.org
All applications will be treated with strictest confidentiality.
________________________________________________
IUSOM Main Campus and Headquarters
International University School of Medicine
Kaya Mòfi 1
P. O. Box # 59
Kralendijk, Bonaire, Caribbean Netherlands (Dutch Caribbean) 0000BQ
The Netherlands, European Union (EU)
Telephone: + 599 - 717 - 6792
Fax: + 599 - 717- 8385
CRIB (Tax) Number at Caribisch Nederland Belastingdienst: 303056514
info@InternationalUniversity-SchoolOfMedicine.org
All information is deemed reliable but is not guaranteed and should be verified
by the viewer.
Copyright © 2005 - 2505 The Trustees of International University School of
Medicine
- IUSOM Faculty Opening in General Pathology